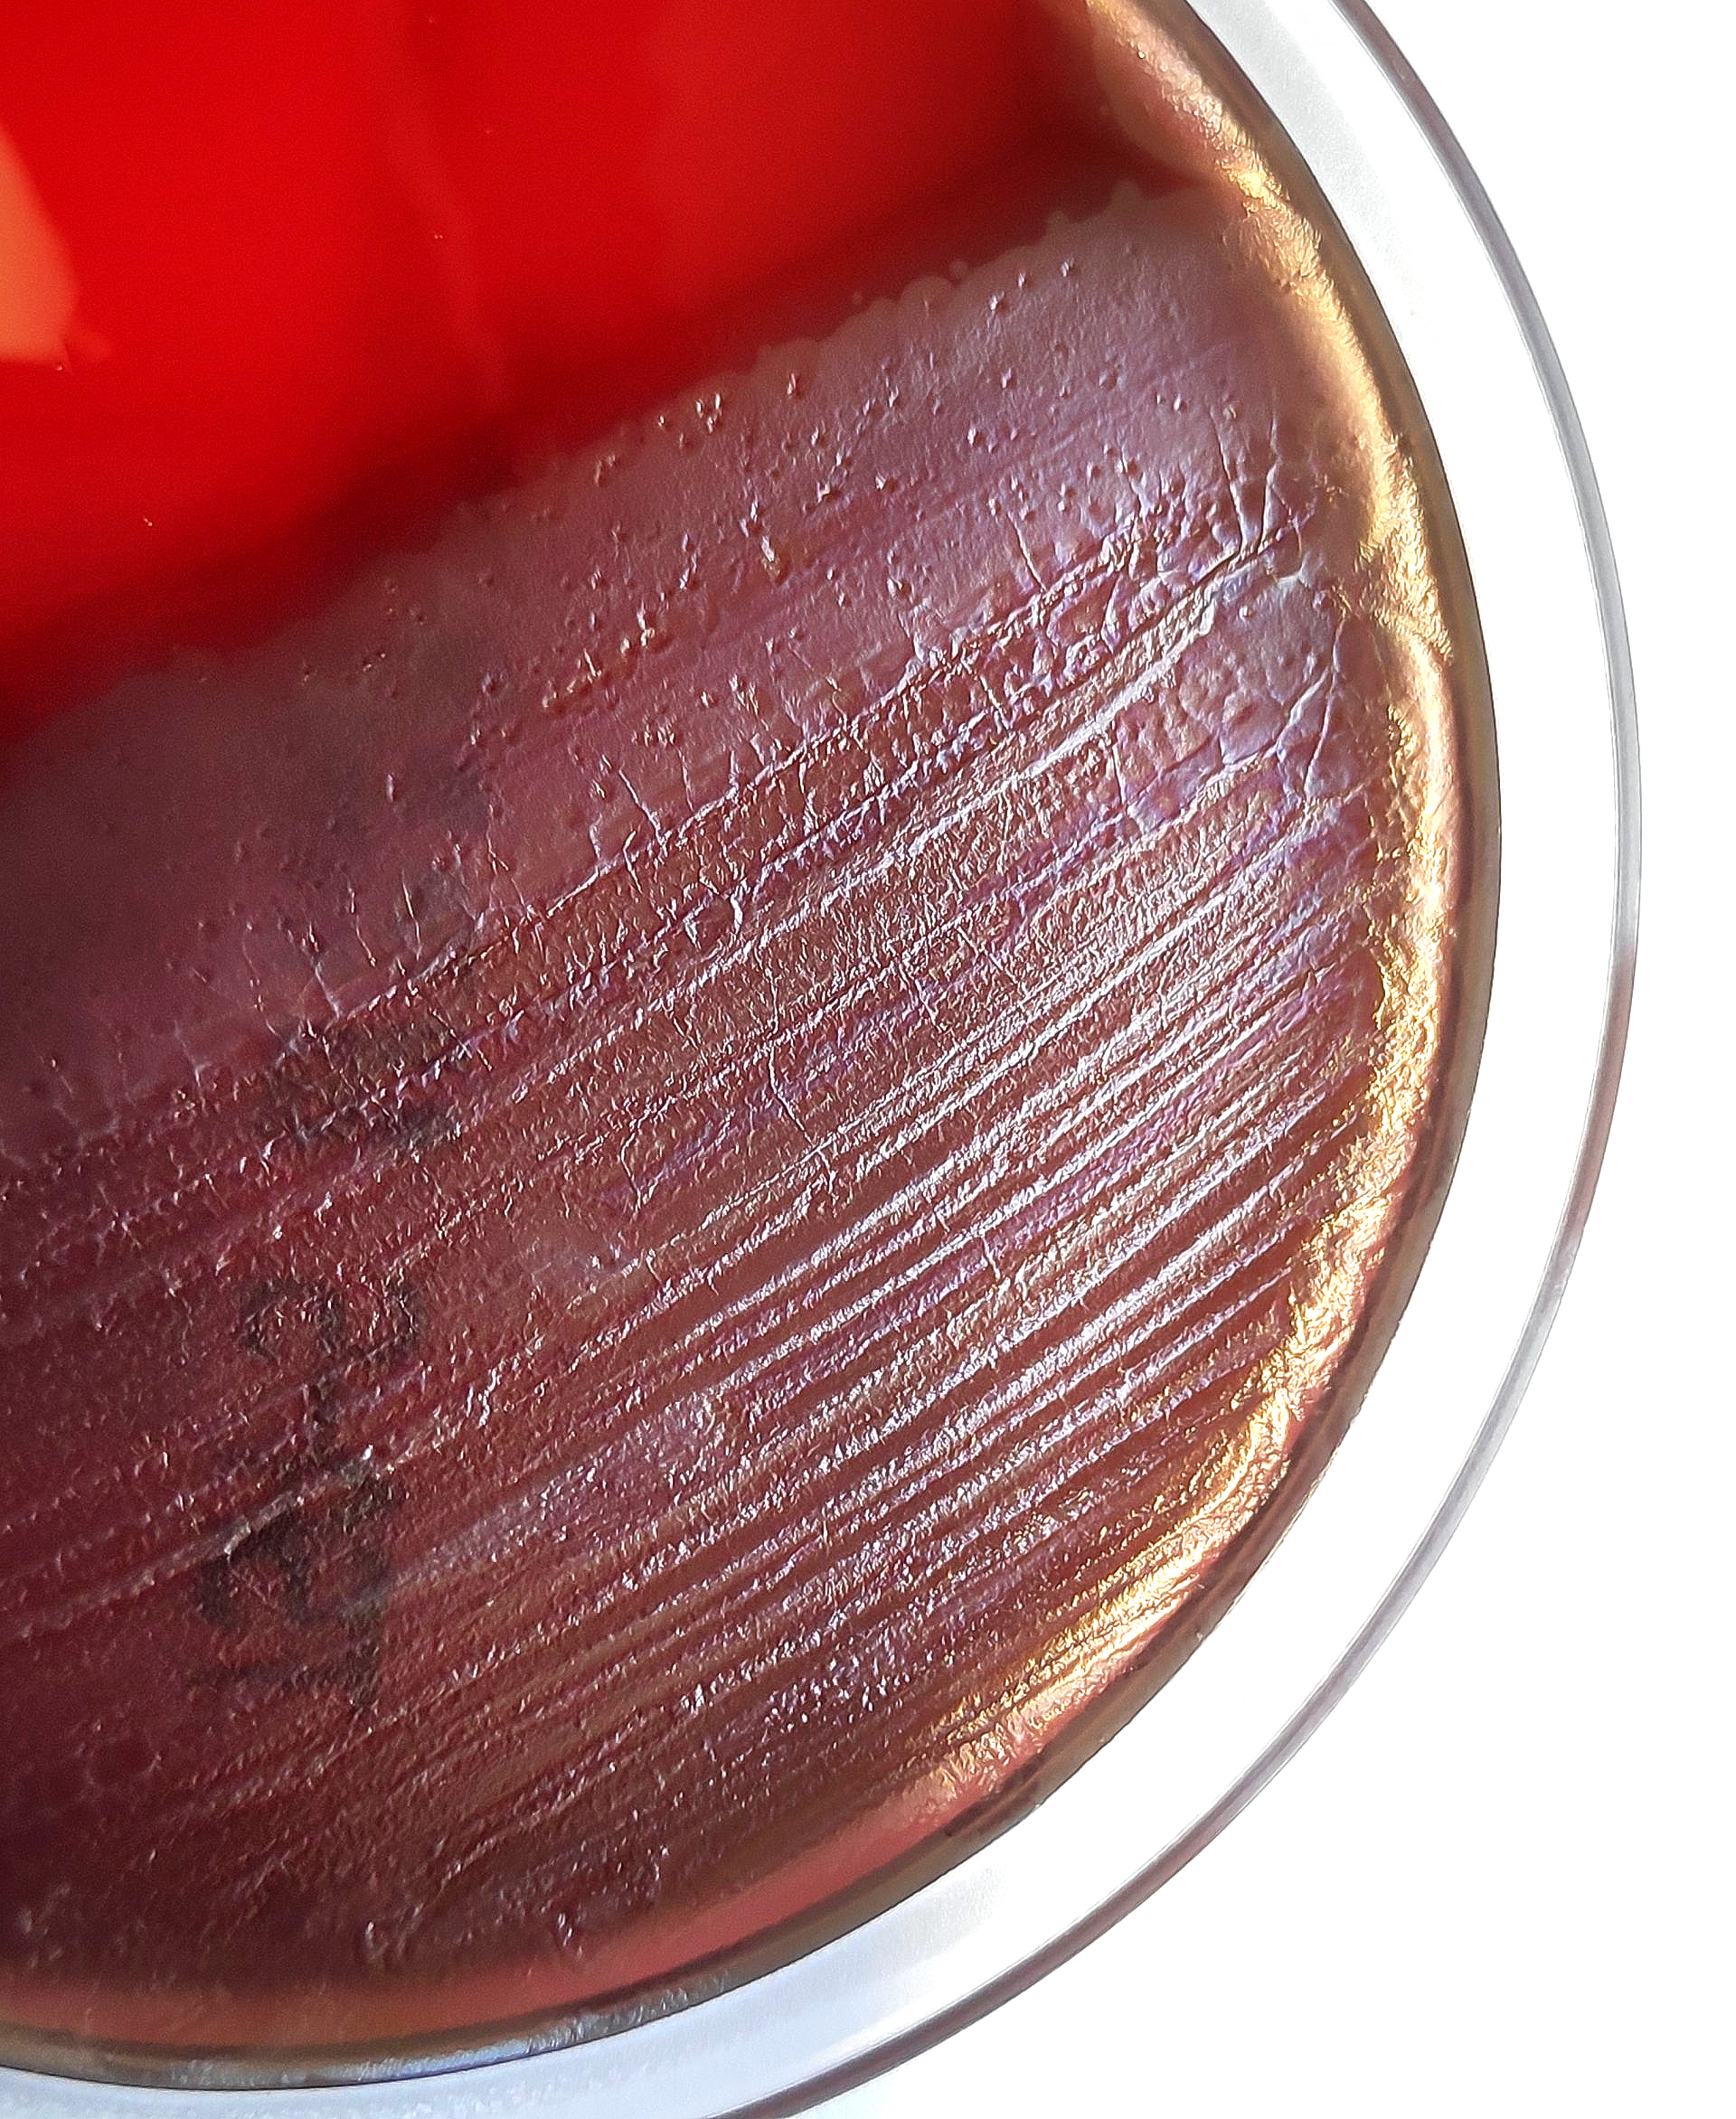
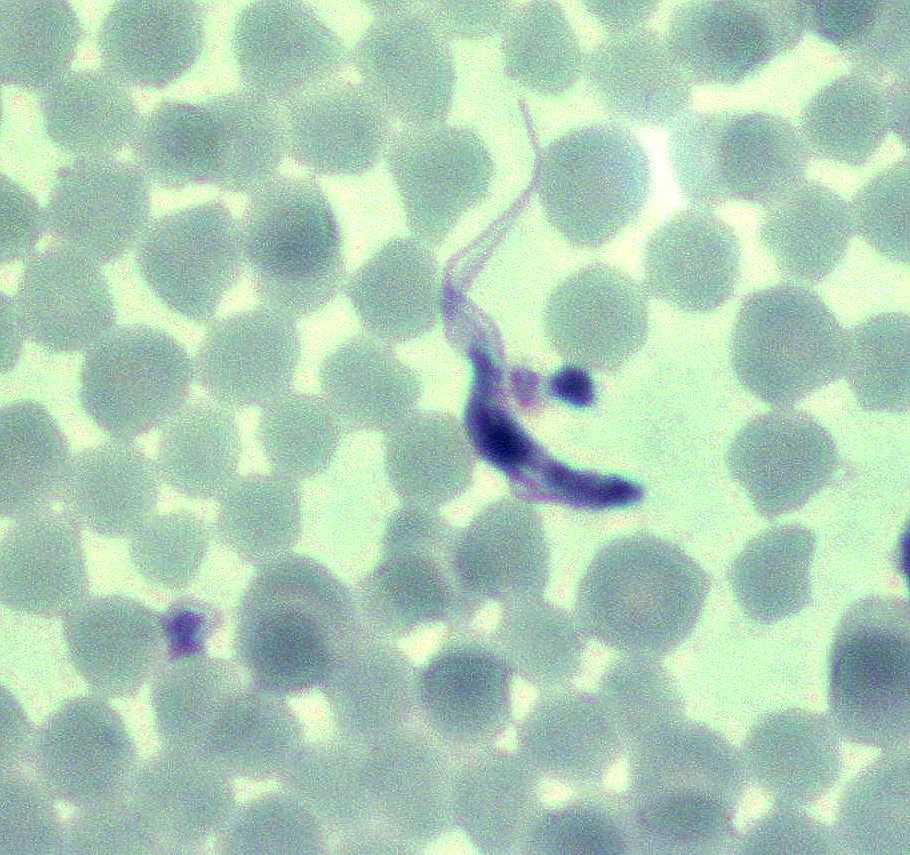

Herzlich Willkommen
im Bereich der Infektionsmedizin
Über uns
Wer ist das Netzwerk Junge Infektionsmedizin (jUNITE)? Was sind unsere Ziele und warum könnte es sich für Dich lohnen bei uns mitzumachen? Erfahre hier mehr über uns.
Veranstaltungen
Was für Termine und Veranstaltungen stehen in der nächsten Zeit an? Informationen zu aktuellen Veranstaltungen findest Du hier.
Kooperationen
Das Netzwerk Junge Infektionsmedizin steht nicht alleine dar. Erfahre hier mehr über assoziierte Fachgesellschaften & Verbände, mit denen das Netzwerk kooperiert.